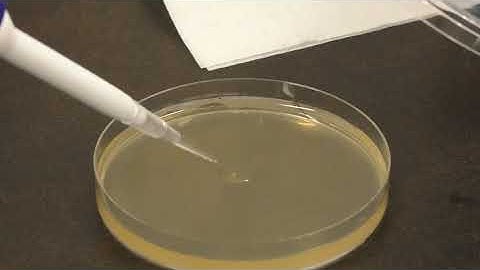
BIOL 303 Video 5 - Spread Plating

⬇ DOWNLOAD NOW
Kalau muncul iklan pop-up, tutup lalu klik tombol kembali
Download lagu Master the Art of Spread Plating: Step-by-Step Guide for Perfect Results 🎯🧫 secara gratis hanya untuk keperluan promosi. Dukung artis favorit kamu dengan membeli musik original di iTunes atau platform resmi lainnya.
 Streak Plate Technique for The Isolation of Pure Culture_A Complete Procedure (Microbiology)
Streak Plate Technique for The Isolation of Pure Culture_A Complete Procedure (Microbiology)
 Spread Plate Technique for Colony Counting_A Complete Procedure (Microbiology)
Spread Plate Technique for Colony Counting_A Complete Procedure (Microbiology)
 Spread Plating
Spread Plating
 How to use Spread Plate technique
How to use Spread Plate technique
 Lab technique microbiology: Streak plate method
Lab technique microbiology: Streak plate method
BIOL 303 Video 5 - Spread Plating
BIOL 303 Video 5 - Spread Plating
 spread plate method | #microbiologyexpeiments
spread plate method | #microbiologyexpeiments
 Microbiology: The spread plate technique
Microbiology: The spread plate technique